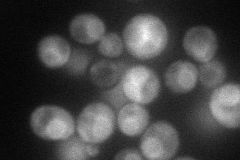
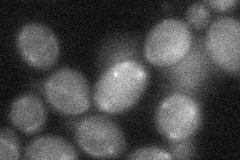
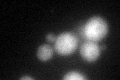
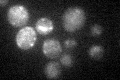

View description
Ubiquitin conjugating enzyme, involved in the ER-associated protein degradation pathway; requires Cue1p for recruitment to the ER membrane; proposed to be involved in chromatin assembly
Localization:
Intensity:
Fold change:
Significance:
-
C’ GFP library in SD

below threshold20.54 -
N' NOP1pr-GFP in SD
cytosol,ER66.1189 -
N' TEF2pr-mCherry in SD

cytosol,nucleus102.091 -
N' NATIVEpr-GFP in SD

ER33.032 -
N' TEF2pr-VC and Cyto-VN in SD
cytosol31.3974 -
C’ GFP library in SD+DTT
cytosol28.851.4Yes -
C’ GFP library in SD+H2O2

cytosol21.351.03No -
C’ GFP library in Starvation Media
cytosol23.891.16No -
C’ GFP library on the background of Pup2-DaMP

below threshold -
C’ GFP library on the background of CCT mutant

below threshold21.98461.07007No
